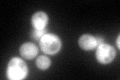
YGR208W
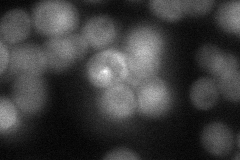
YGR208W
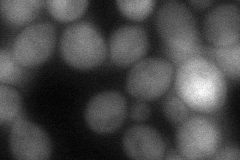
YGR208W
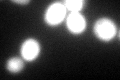
YGR208W
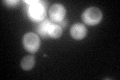
YGR208W

View description
Phosphoserine phosphatase of the phosphoglycerate pathway, involved in serine and glycine biosynthesis, expression is regulated by the available nitrogen source
Localization:
Intensity:
Fold change:
Significance:
-
C’ GFP library in SD
cytosol99.61 -
N' NOP1pr-GFP in SD

cytosol114.564 -
N' TEF2pr-mCherry in SD

cytosol11.66 -
N' NATIVEpr-GFP in SD
cytosol56.1754 -
N' TEF2pr-VC and Cyto-VN in SD
cytosol63.3541 -
C’ GFP library in SD+DTT
cytosol81.260.81No -
C’ GFP library in SD+H2O2
cytosol96.680.97No -
C’ GFP library in Starvation Media

cytosol91.590.91No -
C’ GFP library on the background of Pup2-DaMP

cytosol -
C’ GFP library on the background of CCT mutant

cytosol100.9971.0138No
